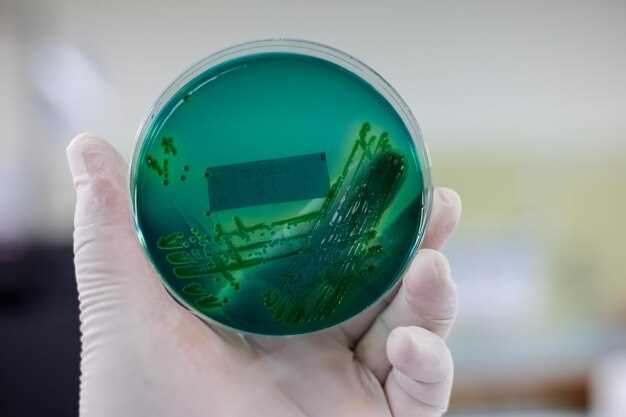

Для успешной борьбы с инфекциями необходимо основательно понимать микробиологическую среду. Патогенные бактерии становятся всё более опасными из-за их способности к резистентности. Многочисленные медицинские исследования показывают, что антибиотикорезистентные штаммы микроорганизмов представляют собой серьезную угрозу для здоровья населения. Применение антибиотиков без необходимости и неправильное лечение способствуют распространению этой проблемы.
Возникающая резистентность бактерий к антибиотикам требует от медицинского сообщества новых стратегий в лечении инфекций. Осознание механизмов, которыми микроорганизмы развивают устойчивость, позволяет разрабатывать альтернативные методы терапии. Постоянный мониторинг штаммов и разработка новых антибактериальных препаратов становятся необходимыми шагами для обеспечения здоровья населения.
Лечение инфекций должно учитывать не только непосредственно возбудителей заболеваний, но и факторы, способствующие распространению резистентных штаммов. Образование, соблюдение правил личной гигиены и рациональное использование антибиотиков — важные аспекты в борьбе с антибиотикорезистентностью. Каждый из нас может сыграть роль в этой глобальной проблеме, улучшая понимание и предотвращая развитие резистентности к антибиотикам.
Микробиология и антибиотикорезистентность
Проводите регулярные медицинские исследования для раннего выявления резистентных патогенных бактерий. Это поможет снизить распространение инфекционных болезней и улучшить здоровье пациентов.
В диагностике важно учитывать, что антибиотики не всегда эффективны против всех бактерий. Использование антибиотиков должно быть строго обосновано, чтобы избежать формирования резистентных штаммов.
Старайтесь применять меры по поддержанию хорошего состояния микрофлоры. Увеличение потребления пробиотиков может играть ключевую роль в борьбе с резистентностью бактерий к антибиотикам, так как крепкая иммунная система эффективнее справляется с инфекциями.
- Регулярно обследуйте пациентов на наличие инфекционных болезней.
- Развивайте программы по образованию медицинских работников о правильном использовании антибиотиков.
- Участвуйте в биомедицинских науках и проектах, направленных на исследование антибиотикорезистентности.
Фиксируйте и анализируйте данные о проявлениях резистентности в вашей медицинской практике для успешного обновления рекомендаций по лечению. Понимание поведения и механизмов бактерий поможет в разработке новых подходов к борьбе с инфекциями.
Причины и механизмы формирования антибиотикорезистентности
Также важным является факт, что микроорганизмы способны обмениваться генами, которые отвечают за резистентность к антибиотикам. Этот процесс, называемый горизонтальным генетическим обменом, позволяет патогенным бактериям быстро адаптироваться к воздействию лекарств.
Среди медицинских исследований возникновение резистентности часто связывают с неполной диагностикой. Если лечение начинается без адекватного определения возбудителя инфекции, это может способствовать выживанию тех бактерий, которые не поддаются терапии.
Кроме того, условия, в которых происходит обработка инфекций, также влияют на уровень резистентности. Неправильное хранение антибиотиков и нарушения в процессе их использования только усугубляют проблему. Неоправданное использование антибиотиков в сельском хозяйстве и ветеринарии расширяет зоны их распространения среди общественных популяций микроорганизмов.
Системный подход к диагностике и лечению инфекций, включая регулярный мониторинг и правильное использование антибиотиков, снижает вероятность формирования устойчивых штаммов. Важно развивать программы по контролю и профилактике антибиотикорезистентности для успешной борьбы с данной проблемой в будущем.
Роль микробиологии в профилактике инфекционных заболеваний
Микробиология помогает в профилактике инфекционных заболеваний через изучение микробов и их взаимодействия с окружающей средой и организмом человека. Основы микробиологии обеспечивают понимание механизмов, которые позволяют бактериям вызывать болезни, а также помогают разработать методы их профилактики.
Современные медицинские исследования в области микробиологии акцентируют внимание на резистентности бактерий к антибиотикам. Эффективное использование антибиотиков и контроль их применения необходимы для предотвращения возникновения устойчивых штаммов. Чтобы избежать проблем с антибиотикорезистентностью, важно применять антибиотики строго по назначению врача.
Применение пробиотиков и пребиотиков становится частью стратегии профилактики инфекционных болезней. Эти препараты поддерживают здоровую микрофлору, что способствует укреплению иммунитета и предотвращению инфекций. Таким образом, внимание к микробиологии помогает создать системы, которые защищают здоровье на уровне популяции.
Образование граждан о роли микробов в жизни человека также снижает риск распространения инфекционных заболеваний. Люди, осведомлённые о методах профилактики, более ответственно относятся к своему здоровью, что влечёт за собой уменьшение заболеваемости.
Современные подходы к лечению инфекций с учетом резистентных бактерий

Используйте комбинацию антибиотиков для повышения эффективности лечения. Сочетание различных классов антибактериальных препаратов позволяет обойти механизмы резистентности патогенных бактерий и улучшить исход лечения инфекций.
Внедряйте клеточную диагностику для точной идентификации патогенов и их резистентных характеристик. Это позволяет выбирать наиболее подходящие антибиотики и минимизировать ошибки в терапии. Современные методы молекулярной диагностики, такие как ПЦР, обеспечивают скорость и точность определений.
Уделяйте внимание биомедицинским наукам и изучению микробиологии. Понимание основ микробиологии помогает выявлять механизмы действия бактерий и адаптироваться к изменениям в их патогенезе. Это повысит осведомленность о текущих угрозах и новых резистентных штаммах.
Разрабатывайте стратегии профилактики инфекций, чтобы уменьшить распространение резистентных бактерий. Вакцинация, соблюдение стандартов гигиены и отслеживание инфекционных вспышек могут существенно снизить уровень заболеваемости и количество случаев, связанных с антибиотикорезистентностью.
Исследуйте альтернативные методы терапии, такие как фаговая терапия и использование природных антимикробных веществ. Эти подходы предлагаются как дополнение к традиционным антибиотикам и показывают перспективные результаты в борьбе с резистентными инфекциями.
Не забывайте о важности образования и информирования населения о правильном использовании антибиотиков. Осведомленность о последствиях неправильного применения антибактериальных средств способствует их разумному использованию и предотвращает дальнейшее развитие резистентности.








